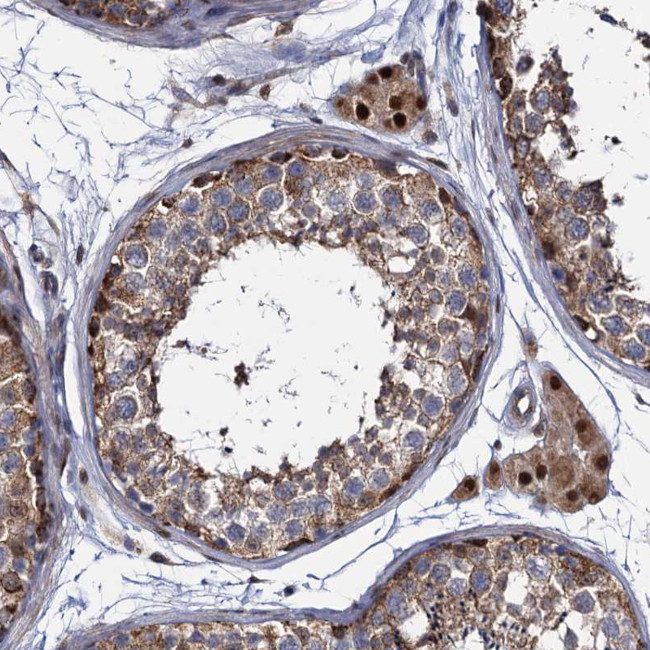
ALKBH7 Antibody in Immunohistochemistry (Paraffin) (IHC (P))

Search
Invitrogen
ALKBH7 Polyclonal Antibody
{{$productOrderCtrl.translations['antibody.pdp.commerceCard.promotion.promotions']}}
{{$productOrderCtrl.translations['antibody.pdp.commerceCard.promotion.viewpromo']}}
{{$productOrderCtrl.translations['antibody.pdp.commerceCard.promotion.promocode']}}: {{promo.promoCode}} {{promo.promoTitle}} {{promo.promoDescription}}. {{$productOrderCtrl.translations['antibody.pdp.commerceCard.promotion.learnmore']}}
产品信息
PA5-58842
种属反应
宿主/亚型
分类
类型
抗原
偶联物
形式
浓度
规格
纯化类型
保存液
内含物
保存条件
运输条件
RRID
产品详细信息
Immunogen sequence: SGPSVLSRLQ DAAVVRPGFL STAEEETLSR ELEPELRRRR YEYDHWDAAI HGFRETEKSR WSEASRAILQ RV
Highest antigen sequence identity to the following orthologs: Mouse - 78%, Rat - 79%.
靶标信息
ALKBH7 (alkB, alkylation repair homolog 7), also known as SPATA11, is a 221 amino acid protein belonging to the alkB family. ALKBH7 is one of many homologs of the Escherichia coli protein AlkB. AlkB functions to protect DNA and RNA against damage from environmental methylating compounds by directly reversing 1-methyladenine (1-meA) and 3-methylcytosine (3-meC) cytotoxic alkylation lesions in DNA and RNA. The enzyme acts by oxidative demethylation, utilizing ferrous iron and alpha-ketoglutarate as cofactors, 2-oxoglutarate as a co-substrate and molecular oxygen as the oxidizing agent. ALKBH7 is encoded by a gene located on human chromosome 19, which consists of over 63 million bases, houses approximately 1,400 genes and is recognizedfor having the greatest gene density of the human chromosomes.
仅用于科研。不用于诊断过程。未经明确授权不得转售。
篇参考文献 (0)
生物信息学
蛋白别名: alkB, alkylation repair homolog 7; Alkylated DNA repair protein alkB homolog 7; Alpha-ketoglutarate-dependent dioxygenase alkB homolog 7, mitochondrial; pre-tRNA N1-methyl adenine demethylase ALKBH7; pre-tRNA N2-dimethyl guanosine demethylase ALKBH7; probable alpha-ketoglutarate-dependent dioxygenase ABH7; RNA demethylase ALKBH7, mitochondrial; spermatogenesis associated 11; spermatogenesis cell proliferation related protein; Spermatogenesis cell proliferation-related protein; Spermatogenesis-associated protein 11; unnamed protein product
基因别名: ABH7; ALKBH7; SPATA11; UNQ6002; UNQ6002/PRO34564
UniProt ID: (Human) Q9BT30
Entrez Gene ID: (Human) 84266